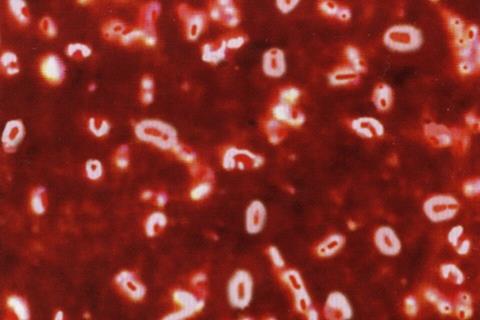

Sepsis and severe pneumonia are frequently accompanied by disruption of the gut microbiota, leading to immune dysfunction and increased susceptibility to secondary infections. Clinical studies have shown that patients with poor outcomes often exhibit reduced microbial diversity and depleted levels of short-chain fatty acids, key metabolites generated by intestinal bacteria.
At the same time, early innate immune responses—particularly those mediated by natural killer cells—are essential for controlling bacterial spread in the lungs. However, how gut-derived metabolites influence immune cell behavior during lung infection has remained unclear. Based on these challenges, it is necessary to conduct in-depth research to clarify how microbial metabolites regulate immune defenses during severe bacterial pneumonia.
Researchers from Zhongshan Hospital of Fudan University reported (DOI: 10.1093/burnst/tkaf069) on January 12, 2025, in Burns & Trauma, that a gut microbiota–derived metabolite can directly shape immune responses in bacterial pneumonia.
Using a Klebsiella pneumoniae infection model, the team demonstrated that butyric acid restores the function of CX3CR1-positive natural killer cells, a population critical for early immune defense in the lungs. By linking gut microbial metabolism to immune cell signaling pathways, the study provides new mechanistic insight into how intestinal health influences outcomes in severe lung infections.
Gut dysbiosis
The researchers first established a microbiota-depleted mouse model to mimic the gut dysbiosis commonly observed in critically ill patients. When these mice were infected with Klebsiella pneumoniae, mortality increased sharply, accompanied by severe lung injury, higher bacterial loads, and reduced production of interferon-γ, a key antimicrobial cytokine. Detailed immune profiling revealed a marked loss of CX3CR1-positive NK cells in the lungs, identifying this cell subset as a critical determinant of host defense failure.

Restoring the gut microbiota through fecal microbiota transplantation reversed these effects. The treatment replenished CX3CR1-positive NK cells, reduced lung damage, and improved survival. Targeted metabolomic analysis further identified butyric acid as the most dramatically altered metabolite associated with immune recovery.
Butyric acid
Direct supplementation with butyric acid reproduced the protective effects of microbiota restoration. Treated animals showed enhanced NK cell migration to the lungs, increased interferon-γ secretion, reduced inflammatory cytokines, and significantly improved survival after infection.
Cellular experiments revealed that butyric acid activates the PI3K/AKT signaling pathway, increasing CX3CR1 expression and strengthening NK cell cytotoxicity and migratory capacity. Pharmacological inhibition of PI3K abolished these effects, confirming a central role for this signaling pathway in the gut–lung immune axis.
“This study demonstrates that immune failure during severe pneumonia is not solely a problem of the lung, but also a consequence of disrupted gut microbiota,” said the senior investigator. “By identifying butyric acid as a key signal that restores NK cell function through CX3CR1 and the PI3K/AKT pathway, we provide a mechanistic explanation for clinical observations linking gut dysbiosis to poor outcomes. These findings suggest that targeting gut-derived metabolites may offer a practical strategy to enhance early immune defense in critically ill patients.”
Restoring immune competence
The findings have important implications for the treatment of severe bacterial pneumonia and sepsis. Rather than focusing exclusively on antimicrobial therapy, future interventions may aim to restore immune competence by modulating the gut microbiota or supplementing specific microbial metabolites.
READ MORE: Gut bacteria protect mice with influenza A from bacterial pneumonia, study finds
READ MORE: In pneumonia’s tug-of-war, lung microbiome could tip the balance
Butyric acid, in particular, could serve as a low-cost adjunct therapy to enhance innate immune responses during the early stages of infection. In addition, CX3CR1 expression on NK cells may emerge as a biomarker to identify patients at high risk of immune dysfunction. Together, these insights support a shift toward microbiota-informed immunomodulatory strategies in critical care.
Topics
- Asia & Oceania
- Bacteria
- butyric acid
- CX3CR1-positive natural killer cells
- Disease Treatment & Prevention
- fecal microbiota transplantation
- Fudan University
- Gut Microbiome
- immune adjuncts
- Immunology
- innate immune responses
- interferon-γ
- Klebsiella pneumoniae
- Metabolomics
- One Health
- pneumonia
- Research News
- sepsis
- Zhongshan Hospital
No comments yet